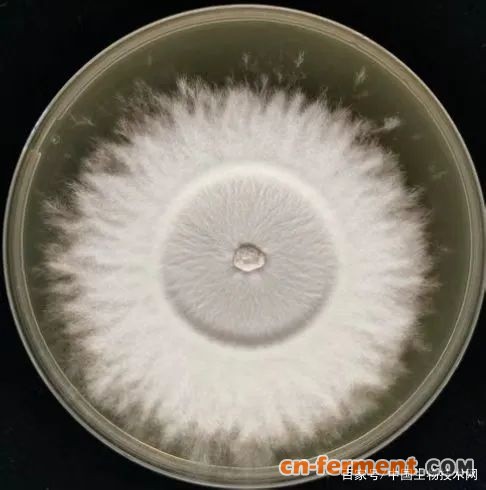
1

1960年代初,在与饥饿斗争的年代,中科院下属单位想方设法扩大粮食代用品开辟粮食饲料来源。其中,微生物所利用白地霉培养出了粮食代用品 “人造肉”,轰动一时。
撰文 | 程光胜
● ● ●
1960年11月间,科研处的王维兴把一个样品送到我们实验室(西楼209),要我分析。这个样品比较特别,大约8立方厘米大小,外表看来像一小块带皮的猪肉。细看一下,猪皮是淀粉做的,“猪皮” 下是像肥肉的一层白色物质,再下面便是用红色染料染成 “瘦肉” 了。
原来这是用我们所发酵工厂出品的 “人造肉” 制成的山寨版猪肉。王维兴说是中南海送来的。我一天后交去了分析结果。具体的分析数据现在找不到了。
那年秋天,北京市场已经出现粮食短缺,北京市居民的粮食定量标准都降低了约15%,兼之副食供应大量缩减,肉类和其他食品也很难在市场买到。人民普遍营养不良,许多人肢体出现水肿。但是当时绝大多数人并不了解全国的情况,始终以为全国形势一片大好,三面红旗万岁,饥饿只是暂时的。
“低标准,瓜菜代”,这是当时解决粮食不足的方针。微生物所推出的粮食代用品是 “人造肉” 和 “稻草曲”,颇为轰动。所谓 “人造肉”,是用廉价原料培养的微生物细胞代替动物肉类食品的俗称,现在一般使用的名词叫做 “单细胞蛋白”。本文只谈 “人造肉”。
早在群众感受到粮食困难之前,显然领导们都已经了解到局势之严峻。1960年6月26日至30日,中国科学院在北京香山饭店召开了扩大粮食代用品开辟粮食饲料来源问题会议。出席会议的有生物学部的17个研究单位,还有其他学部,以及武汉、兰州分院等单位的人员共60余人,由时任副秘书长秦力生主持。
微生物所在6月17日后接到院党组通知,要求 “党员副所长和有关这方面的党员或党外左派科学家1至2人,携带国内外工作进行情况的有关资料参加会议。”
微生物所的方心芳和党委书记林一夫两位副所长参加了会议。方心芳在会上提供了关于人造肉的资料,在方心芳遗存的笔记本上也看到他写了 “人造肉” 3个字。这是我所在方心芳领导下开始制作 “人造肉” 项目的开端。
院里这次会议共提出了18个重要项目,76个研究题目,分为5类,包括野生植物和农副产品的扩大利用、水体浮游生物作为粮食或饲料、研究化学合成糖类、研究粮食作物、家畜、鱼、虾的增产措施,以及从空气固氮等。总之是要千方百计增加食物,解决大范围的饥饿问题。
会后院党组指定由秦力生、恽子强、过兴先、朱济凡、刘绠、林一夫、孙自平、赵毅、成解、姜纪五、刘矫飞等11位同志组成领导小组,具体领导这项工作,并由秦力生任组长,恽子强、过兴先任副组长。
会议指出“积极支援农业是有关研究单位的中心任务之一”, 要求各研究所立即适当抽调力量,“每一个题目组成一个战斗队伍,积极展开工作。”
后来生物学部又整理出关于扩大粮食代用品,开辟粮食和饲料新来源会议的报告,7月27日由院党组向各研究单位领导小组(党委)转发。这份报告附上了重要项目名称和主要负责单位。
项目中的第四项便是 “人造肉”,主要负责单位是微生物所,参加单位是武汉微生物室、沈阳林土所、北京植物所、化学所、生物物理所和化工冶金所。该报告要求各研究所当前侧重短期内即可完成的项目,力求在今年内作出一批成果,以帮助某些地区群众渡过明年可能出现的春荒。
会议之后,方心芳作了大量文献调查,在工业室布置酵母菌组和官选民进行利用戊糖生长的酵母菌的筛选和生长量试验,官选民筛选了我所保藏的456株酵母菌,优选到编号为2.361的白地霉(Geotrichum candidum)作为菌种,然后又进行了营养条件试验,培养基的碳氮比为30:1。
笔者当年7月在方心芳的办公室(西楼202)开会时已经确定用该菌种开始制备 “人造肉”。
当时,在中关村东边,京张铁路西边微生物所有一片试验地,除供大田试验的田地外,还有温室和准备进行丙酮丁醇发酵的中试车间,几个240升的碳钢的发酵罐也已现成,正好可以用来进行酵母菌培养。从1960年10月起,由方心芳任技术总指挥的 “人造肉” 制造工厂开工了。
在所党委的领导下,参加工作的各类人员当在50人以上,许多1960年由高校分配来的大学毕业生,报到后便前去人造肉车间工作了。技术上分水解组、发酵组和设备组。水解组定员13人,由严自正、谢舜珍负责,任务是用酸水解稻草、玉米芯等,提供培养原料;发酵组21人,由乐华爱负责,任务是看管发酵罐的运转,根据酵母菌生长情况采取相应措施,到酵母菌生长到最大限度时,将酵母菌从罐中放出,再用粗布像做豆腐那样过滤出酵母菌菌体,然后在60度高温下让酵母菌细胞自溶分解,释放出细胞中的物质,压干成产品,必要时则将它们烤干;设备组由陆东莱和钟耀明负责,保证器材供应。
原料和成品的基本营养成分则由工业微生物室的分析室承担,这是我和一批实验员的任务,记得张绍恺、赵敬稳、张玲稳等都参加过工作。“人造肉车间” 24小时不停运转了好几个月,每天出产一批,大约几十公斤鲜菌体。开始运转期间,方心芳几乎每天早上天未亮前都会从他的住地骑自行车前去现场,查看生产情况。
经过3个月的工作,各所都有所成就。10月25日至29日中国科学院在西苑饭店召开了粮食与饲料代用品会议,由时任副秘书长的谢鑫鹤主持会议。会议的主要目的,是交流经验,肯定成果。会议肯定的成果有十方面:肯定了一批可以推广的成果时,他说经过肯定的成果,归纳起来有几个方面:野生植物、树叶、野草、水草叶子的利用;叶蛋白;农作物藁杆粉;农作物副产品经过微生物发酵做食品或饲料;农作物根粉;野生植物淀粉;野生油料植物;食用和饲料酵母;小球藻、栅藻、扁藻之类;红虫。
会议还特别强调要加强分析工作和进行动物试验,经过慎重试验,最后自己吃吃,过三关后再推广。指出如果由于科学机构推广成果的粗枝大而造成群众食用代用品的中毒事故,就会有极大的不良影响,但是也要反对无穷忧虑,过于慎重。
在会议期间同时举办了一个小型内部展览会,展出了 “人造肉”、橡子面、小球藻、叶蛋白、农副产品的加工品(玉米芯、稻草等)、野生植物和野生动物(如红虫,学名水蚤)等7类粮食代用品。
这个展览会是为参加会议者准备的,反应不错,到会同志反映会开得比较踏实,不但听到了经验,还看到和吃到了东西;既看到研究的过程,也带回了一些东西,像菌种、资料等。中央的负责同志参观了展览。
10月27日,参观同志给中央领导写了一个报告,介绍了小球藻、又详细介绍了科学院的这次粮食代用品会议,提到8种粮食代用品,其中关于微生物所的成果,有一节,题目是 “一种营养价值高的 ‘人造肉精’ ”,写道:
“科学院微生物研究所,最近研究出一种可以代替副食品的食用酵母菌—— ‘白地霉’,营养价值很高,含蛋白质百分之三十五左右,脂肪百分之十三——十九,与肉类差不多。可以做成汤,味道尚鲜。所以有人叫它 ‘人造肉精’。新鲜的 ‘白地霉’ 是浆状的,可以做成粉,便于储藏。制造白地霉的原料来源广,可以用淘米水、废蔬菜、烂水果、酒糟等。用 ‘土’ 办法制造。适宜在城乡人民公社食堂普遍推广。”
他还较详细地介绍了人造肉精的制法。当天,中央领导在报告上批示道:“印发各中央局、各省、市、区党委第一书记研究、推广”。
为了向中央领导汇报,展览会移到北京饭店,参观者有朱德、罗荣桓、邓颖超、帅孟奇、李立三等。后来根据中央指示,要在中央国家机关范围内首先开始大搞代食品,于是中国科学院生物学部和国务院机关事务管理局合作,于1960年11月7日到13日,在管理局礼堂举办了 “粮食及饲料代用品展览会”。要求中直系统、中央国家机关系统、军委系统和北京市系统的党委书记、行政负责人带上最多3名伙食管理员及炊事员参观。
当时来北京参加国务院召开的代食品会议的全国各地的代表也前去参观。这次展览参观人数超过5000人,谢觉哉、郭沫若、鲍尔汉、翦伯赞、范文澜、竺可桢等都前去参观了。这次展览除上述展品外,还进行了 “人造肉”、小球藻、橡子面和叶蛋白4种代食品的现场制作表演。方心芳为参加观摩和培训的人员讲了课,肖永澜、乐华爱和所内14位同志在会场演示了人造肉的制作和烹调方法。
到60年年底,产品已经提供给许多部门。方心芳曾亲自在多处作报告,参加北京市领导机关的座谈会,为各工厂生产人造肉中出现的问题出谋划策,这些都可在方心芳留下的笔记本中看到。
从院党组1960年11月9日给中央的报告得知,当时还安排了摄制记录影片,据严自正教授回忆,她就曾作为 “演员” 表演和讲解过人造肉的制作过程。相信今天还能在电影博物馆找到那份拷贝。微生物所的员工则在节日期间,每人可以享用半斤鲜 “人造肉”。
很快,人造肉在全国推广。据档案,1960年我所菌种保藏组共转接过16389株酵母菌(那时没有冷冻干燥管),其中绝大多数是白地霉。向全国无偿散发的菌种为9014株,还出售过2100株(每株1元),其中也主要是白地霉。在我国菌种保藏工作中,那是外发菌种数量空前绝后的记录,以后一般不会超过一千株,直到今天。
通过党中央的宣传,人造肉在全国许多地方推广,制品成为高级营养品,据说首次攀登珠穆朗玛峰的登山队员就吃过。当年在北京前门大街上还出现过 “人造肉饺子店”,生意红火了几年。
在与饥饿斗争的年代,微生物所作出了自己突出的贡献,不仅让中央首长知道了人造肉,还让全国人民知道微生物的大用处。微生物所受到院领导的重视和表彰,奖给所里一辆解放牌大卡车,这在当时是相当重的奖励了。
1961年夏天以后,人造肉的生产不再在微生物研究所进行,但是,乐华爱等人又前往北京市的几个副食品生产工厂,例如田村酿造厂和清河粉丝厂等,利用这些工厂的废水试验培养白地霉。到1970年前后,全国许多地方采用微生物所开发的白地霉生产方法生产饲料酵母。
在生产 “人造肉” 抵抗饥饿的同时,微生物所也开展了一些有关白地霉的科学研究。最突出的是张树政领导的微生物代谢研究小组,他们研究了白地霉的戊糖和己糖代谢。阐明了木糖和阿拉伯糖的代谢途径。纯化了木糖醇脱氢酶,并证明为诱导酶。发现白地霉中有甘露醇,阐明了它的合成途径,发现并纯化了依赖辅酶Ⅱ的苷露醇脱氢酶。
我保存了一份当年从事代食品成分分析的方法和主要分析结果汇总表,原件已交给科技档案室保存。现附在文后,读者可以从中知道一些细节。

作者简介









